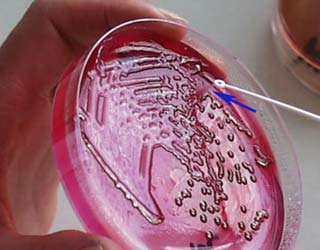

Theo Tổ chức Y tế thế giới (WHO) từ 14-20/11/2016 là "Tuần lễ nâng cao nhận thức về kháng kháng sinh thế giới năm 2016" (World Antibiotic Awareness Week 2016) nhằm nâng cao nhận thức về kháng thuốc kháng sinh toàn cầu (global antibiotic resistance) và khuyến khích thực hành tốt nhất trong cộng đồng, nhân viên y tế và các nhà hoạch định chính sách để tránh xuất hiện mới và lan rộng kháng kháng sinh.
"Thuốc kháng sinh: Hãy dùng cẩn thận"(Antibiotics: Handle with Care)
Đây cũng là chủ đề của chiến dịch được WHO đưa ra từ năm 2015 nhằm chuyển tải thông điệp tổng quát kháng sinh là một nguồn tài nguyên quý giá cần được bảo tồn và chỉ nên sử dụngđiều trị nhiễm trùng do vi khuẩn hay chỉ định theo đơn bác sĩ, thuốc kháng sinh không bao giờ được chia sẻ cho người khác hoặc giữ lại để dùng về sau. Tuy nhiên, để đối phó với tình trạng kháng kháng sinh (AMR) ngày càng lan rộng không chỉ riêng gì trách nhiệm của ngành y tế mà cần có sự phối hợp của ngành nông nghiệp và thú y. Chính vì vậy tháng 5/2015, "Kế hoạch hành động toàn cầu giải quyết vấn đề kháng kháng sinh" đã được Đại Hội đồng Y tế thế giới (WHA) lần thứ 68 thông qua với sự hỗ trợ của Tổ chức nông nghiệp và lương thực (FAO) Liên Hợp Quốc và Tổ chức Thú y thế giới (OIE) mà một trong những mục tiêu chính của kế hoạch là nâng cao nhận thức và hiểu biết về kháng kháng sinh thông qua hiệu quả truyền thông, giáo dục và đào tạo. WHO khuyến khích tất cả các quốc gia thành viên, đối tác y tế và thú y, sinh viên và cộng đồng tham gia chiến dịch này và giúp nâng cao nhận thức về kháng kháng sinh; đồng thời hỗ trợhàng loạt nguồn lực có sẵn để thúc đẩy các chiến dịch tại địa phương và cung cấp tài liệu bổ sung cho các hoạt động trong "Tuần lễ nâng cao nhận thức về kháng thuốc kháng sinh năm 2016".

80% dư lượng kháng sinh trong chăn nuôi
Thực trạng AMR (AMR situation)
WHO cho rằng AMR đang diễn ra ở khắp nơi trên thế giới, ảnh hưởng đến khả năng điều trị các bệnh nhiễm khuẩn và phá hủy những tiến bộ đạt được trong lĩnh vực y tế;bệnh nhân bị nhiễm trùng do vi khuẩn kháng thuốc có diễn biến lâm sàng nặng hơn, nguy cơ tử vong cao hơn và nguồn chi phí chăm sóc sức khỏe nhiều hơn bệnh nhân không bị nhiễm khuẩn kháng thuốc. WHO ước tính mỗi năm thế giới có 700.000 người tử vong do AMR cao hơn ung thư, đái tháo đường và tai nạn giao thông; dồng thời cảnh báo nếu không có những hành động thiết thực ngăn chặn AMR thì tới 2050 sẽ có khoảng 10 triệu người chết hàng năm do nhiễm các loại siêu vi khuẩn kháng thuốc. Trong đó, phải kể đến một số AMR như sau:
Hình 2
Klebsiella pneumoniae
Klebsiella pneumoniae tác nhân chính gây nhiễm khuẩn bệnh viện như viêm phổi (pneumonia), nhiễm trùng máu (bloodstream infections), nhiễm trùng trẻ sơ sinh (infections in newborns), bệnh nhân ở đơn vị chăm sóc chuyên sâu (intensive-care unit patients); đồng thời là vi khuẩn đường ruột phổ biến có thể gây nhiễm trùng đe dọa tính mạng đã kháng vớicarbapenem antibiotics, vũ khí điều trị cuối cùng đã lan rộng hầu khắp các vùng trên thế giới.

Hình 3
Entamoeba coli
Entamoeba coli chủ yếu gây bệnh đường ruột kháng fluoroquinolone antibiotics,một trong những kháng sinh phổ biến điều trị nhiễm trùng tiết niệu đã mất hiệu lực trong hơn 50% số bệnh nhân toàn cầu. Đặc biệt, Colistin-trị liệu cuối cùng nhiễm trùng đe dọa tính mạng doEnterobacteriaceaekháng carbapenem gần đây được phát hiện kháng E.coli ở một số quốc gia và khu vực, nhất là sự kiệnmột ca bệnh nữ 49 tuổi ở Hoa Kỳ nhiễm vi khuẩnE.colihiếm gặp và không có thuốc điều trị trong năm 2016 làm dấy lên mối quan ngại “siêu vi khuẩn" (superbugs) kháng thuốc ngày càng lan rộng và vô phương cứu chữa.

Hình 4
Staphlylococcusvà các bệnh truyền qua đường tình dục (Sexually transmitted infections_STI)
Sự kháng các thuốc hàng đầu điều trị nhiễm trùng Staphlylococcus aureus, nguyên nhân nhiễm trùng phổ biến ở các cơ sở y tế cũng như cộng đồng, WHO ước tính 64% số người nhiễm methicillin-resistant Staphylococcus aureus (MRSA) nhiều khả năng tử vong hơn những người nhiễm trùng không bị kháng. Thất bại điều trị (Treatment failure)với thuốc cuối cùng điều trị bệnh lậu kháng sinh cephalosporin thế hệ thứ ba (third generation cephalosporin antibiotics)đã được xác nhận ít nhất ở 10 quốc gia (Australia, Austria, Canada, Pháp, Nhật Bản, Na Uy, Slovenia, Nam Phi, Thụy Điển, UK và Bắc Ireland).

Hình 5
Lao đa kháng thuốc (MDR-TB)
Trong năm 2014, WHO ước tính 480.000 ca mắc mới lao đa kháng thuốc (MDR-TB) kháng cả 2 loại thuốc chống lao mạnh nhất hiện nay nhưng chỉ 123.000 trường hợp (khoảng 25%) được phát hiện và báo cáo. MDR-TB đòi hỏi thời gian điều trị dài hơn, kém hiệu quả hơn so với lao không kháng thuốc và chỉ 50% số trường hợp MDR-TB được điều trị thành công. Kháng thuốc diện rộng bệnh lao (XDR-TB) kháng lại ít nhất 4 loại thuốc chống lao cốt lõi đã được xác định ở 105 quốc gia với ước tính khoảng 9,7% bao gồm cả MDR-TB và XDR-TB.

Hình 6
Kháng thuốc sốt rét (Resistance in malaria)
Từ hàng chục năm nay,P.falciparumđược xác định là chủng đa kháng thuốc sốt rét như chloroquine, Fansidar (sulfadoxine/pyrimethamine); thậm chí kháng cả các thuốc có hiệu lực cao như mefloquine, artemisinine. Đến 2016, P.falciparumkháng trị liệu kết hợp artemisinin (ACTs) ở 5 quốc gia Tiểu vùng sông Mekong (GMS) bao gồm Cambodia, Lao PDR, Myanmar, Thailand và Việt Nam). Đặc biệt khu vực biên giới Thailand-Cambodia, P.falciparumđã kháng với hầu hết các thuốc chống sốt rét có sẵn gây trở ngại cho việc điều trị. WHO cảnh báo chủng kháng (spread of resistant strains)P.falciparumtiếp tục lan rộng ra phần còn lại GMS và các nước có lưu hành sốt rét trên thế giới, nhất là châu Phi là một thách thức y tế công cộng cũng như khó kiểm soát sốt rét.

Hình 7
Kháng thuốc HIV (Resistance in HIV)
Từ 2015, WHO khuyến cáo tất cả mọi người sống chung với HIV bắt đầu điều trị thuốc kháng virus (ARV) và dự báo sử dụng nhiều hơn ART sẽ làm tăng sức đề kháng ARV ở phạm vi toàn cầu. Trong khi từ năm 2010, WHO ước tính khoảng 7% số người bắt đầu điều trị ARV ở các nước đang phát triểncó HIV kháng thuốc; 10-20% ở các nước phát triển. Ngoài ra, một số quốc gia gần đây đã báo cáo mức độ ≥ 15% trong số những người bắt đầu điều trị HIV (starting HIV treatment)và lên tới 40% trong số những người bắt đầu điều trị lại (re-starting treatment)đòi hỏi sự chú ý khẩn cấp. Sự gia tăng mức độ kháng thuốc đã tác động kinh tế quan trọng tới các phác đồ tuyến hai và ba (second and third-line regimens)đắt hơn từ 3 đến 18 lần so với các thuốc ưu tiên tuyến đầu (first-line drugs).

Hình 8
Lạm dụng quá mức kháng sinh (misuse and overuse of antimicrobials)
AMR diễn ra tự nhiên theo thời gian thông qua những thay đổi di truyền (genetic changes)nhưng sự lạm dụng quá mức kháng sinh (misuse and overuse of antimicrobials)làm đẩy nhanh quá trình này. Ở nhiều nơi, kháng sinh bị lạm dụng cả ở người và động vật thường được đưa ra mà không có sự giám sát chuyên nghiệp như chỉ định điều trị sai khi các thuốc kháng sinh được sử dụng cho những người bị nhiễm virus như cảm lạnh (colds), cúm (flu)và được dùng cho kích thích tăng trưởng (growth promoters)ở động vật và cá. Vi khuẩn AMR được tìm thấy ở người, động vật, thực phẩm và môi trường (trong nước, đất và không khí) có thể lây lan giữa người và động vật (spread between people and animals), từ người này sang người khác (from person to person). Kiểm soát nhiễm khuẩn nghèo nàn, điều kiện vệ sinh không đầy đủ và xử lý thực phẩm không an toàn tạo điều kiện thuận lợi cho sự lan tràn của AMR. Chính vì vậy, sự lạm dụng kháng sinh có thể được coi là nguyên nhân hàng đầu dẫn đến AMR mà trước tiên phải kể đến ý thức của cộng đồng, trách nhiệm y tế và nông nghiệp. Về ý thức cộng đồng, theo Bộ Y tế (MOH) tình trạng lạm dụng kháng sinh ở Việt Nam đã đạt mức báo động vì chỉ cần có tiền là có thuốc, khi 88% người dân ở thành thị và 91% ở nông thôn tự mua thuốc kháng sinh điều trị mà không cần chẩn đoán hoặc kê đơn của thầy thuốc. Trong đó, 3 loại thuốc kháng sinh được bán nhiều nhất là ampicillin/amoxicillin (29,1%), cephalexin (12,2%) và azithromycin (7,3%) về sử dụng tùy tiện, không đủ liều, không đủ ngày, thậm chí các bệnh thông thường cũng dùng kháng sinh. Bên cạnh đó, tình trạng lạm dụng kháng sinh cũng thường gặp ở các cơ sở y tế do các thầy thuốc "điều trị bao vây" đến 2-3 loại kháng sinh mà không càn quan tâm đến sử dụng thuốc trước đó của bệnh nhân. Cùng với đó, việc sử dụng nhiều thuốc kháng sinh trong chăn nuôi làm thực phẩm tồn dư lượng kháng sinh người sử dụng cũng có nguy cơ AMR.
Úng phó của WHO và MOH

Hình 9
Kế hoạch hành động toàn cầu về kháng kháng sinh (Global action plan on antimicrobial resistance)
Từ nhận thức kháng sinh là thuốc chuyên dụng ngăn ngừa và điều trị các bệnh nhiễm trùng do vi khuẩn gây nên, kháng thuốc kháng sinh xảy ra khi vi khuẩn thay đổi đáp ứng với các loại thuốc này là một trong những mối đe dọa lớn nhất với sức khỏe toàn cầu hiện nay; đồng thời đặt ra thách thức lớn với sức khỏe, an ninh lương thực và phát triển có thể ảnh hưởng đến bất kể người nào, độ tuổi nào và quốc gia nào. Phiên họp lần thứ 68 tháng 5/2015, WHA đã thông qua một kế hoạch hành động toàn cầu giải quyết kháng kháng sinh với mục tiêu đảm bảo càng lâu càng tốt, liên tục điều trị khỏi các bệnh nhiễm khuẩn bằng các thuốc kháng sinh có hiệu quả, an toàn, đảm bảo chất lượng và có trách nhiệm với tất cả những ai dùng chúng.

Hình 10
Để đạt được mục tiêu này, kế hoạch hành động toàn cầu đặt ra 5 mục tiêu chiến lược bao gồm nâng cao nhận thức và hiểu biết về kháng kháng sinh (to improve awareness and understanding of antimicrobial resistance); củng cố kiến thức thông qua giám sát và nghiên cứu (to strengthen knowledge through surveillance and research); làm giảm tỷ lệ nhiễm trùng (to reduce the incidence of infection); tối ưu hóa việc sử dụng các tác nhân kháng khuẩn (to optimize the use of antimicrobial agents);phát triển kinh tế cho đầu tư bền vững trong đó xem xét các nhu cầu của tất cả các nước, tăng cường đầu tư trong các loại thuốc mới, các công cụ chẩn đoán, vaccine và các can thiệp khác (develop the economic case for sustainable investment that takes account of the needs of all countries, and increase investment in new medicines, diagnostic tools, vaccines and other interventions). WHO phát triển kế hoạch và hướng dẫn này dựa trên khuyến nghị của các quốc gia, các bên liên quan và một số vấn nhiều bên tại các diễn đàn toàn cầu và khu vực khác nhau.

Hình 11
Hưởng ứng của Việt Nam
Hưởng ứng "Tuần lễ nâng cao nhận thức về kháng thuốc kháng sinh thế giới năm 2016", ngày 29/11/2016 MOH phối hợp với WHO và FAO phát động "Tuần lễ nâng cao nhận thức về sử dụng thuốc kháng sinh lần thứ 2 ở Việt Nam" từ 30/11 đến 7/12/2016 với chủ đề “Chung sức chống tình trạng kháng thuốc kháng vi sinh vật mạnh mẽ hơn nữa” nhằm tăng cường cam kết ở cấp quốc gia chống AMR.

Lãnh đạo Bộ Y tế phát biểu tại Lễ phát động tuần lễ phòng chống AMR
Tại lễ phát động, Lãnh đạo Bộ Y tế chỉ rõ AMR đang đe dọa sức khỏe con người và làm giảm hiệu quả điều trị, trong đó Việt Nam hiểm họa này ngày càng lớn hơn do tình trạng lạm dụng kháng sinh khó kiểm soát trong cộng đồng, y tế, thú y, tồn dư kháng sinh thực phẩm cũng như môi trường sống. Hơn nữa, ở nước ta mức độ vi khuẩn kháng đa thuốc gia tăng nhất cùng với nhóm vi khuẩn gram âm đã biến đổi gen đa kháng với carbapenem thế hệ mới nên Việt Nam được WHO xếp vào nhóm nước có tỷ lệ AMR cao nhất thế giới. "Tuần lễ nâng cao nhận thức về thuốc kháng sinh" là cơ hội nâng cao nhận thức của cộng đồng, y tế, nông nghiệp, các nhà hoạch định chính sách và ban ngành hữu quan. Đối với cộng đồng, WHO khuyến cáo chỉ sử dụng kháng sinh theo đơn bác sĩ, dùng thuốc đúng và đủ liều quy định, không chia sẻ thuốc kháng sinh hoặc dành lại để dùng về sau. Đối với lĩnh vực y tế, cần tăng cường kiểm soát và phòng chống nhiễm khuẩn, chỉ định kháng sinh khi thực sự cần thiết và đúng bệnh. Đối với lĩnh vực thú y và nông nghiệp cả 3 tổ chức quốc tế WHO, FAO và OIE đều cho rằng sử dụng kháng sinh trong nuôi trồng thủy sản chịu trách nhiệm một phần gia tăng kháng thuốc; để giảm thiểu lượng kháng sinh trong nuôi trồng cần có chuyên gia quốc tế hướng dẫn xây dựng mục tiêu thực hiện; đồng thời tham gia tích cực hoạt động của OIE để xác định các lỗ hổng nghiên cứu phát triển vaccine mới cho cá nuôi cũng như các loài động vật cùng các mục tiêu giảm sử dụng kháng sinh phù hợp cho từng lĩnh vực vào năm 2017 mà mức giảm cao nhất sẽ là nền tảng cho việc thực hành tốt nhất và sử dụng có trách nhiệm các loại thuốc kháng sinh và bảo vệ sức khỏe động vật.Các nhà hoạch định chính sách và ngành công nghiệp cần tăng cường theo dõi kháng và năng lực phòng thí nghiệm, điều tiết và thúc đẩy sử dụng thuốc thích hợp; khuyến khích cải tiến, nghiên cứu và phát triển các công cụ mới, đẩy mạnh hợp tác và chia sẻ thông tin.